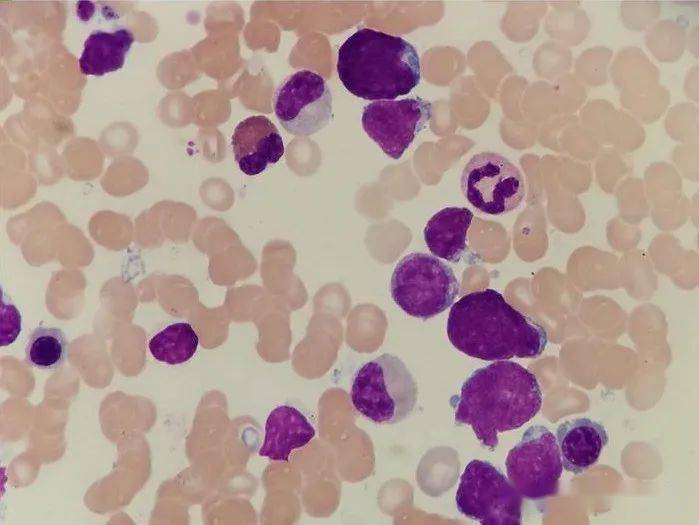
弥漫大b细胞淋巴瘤
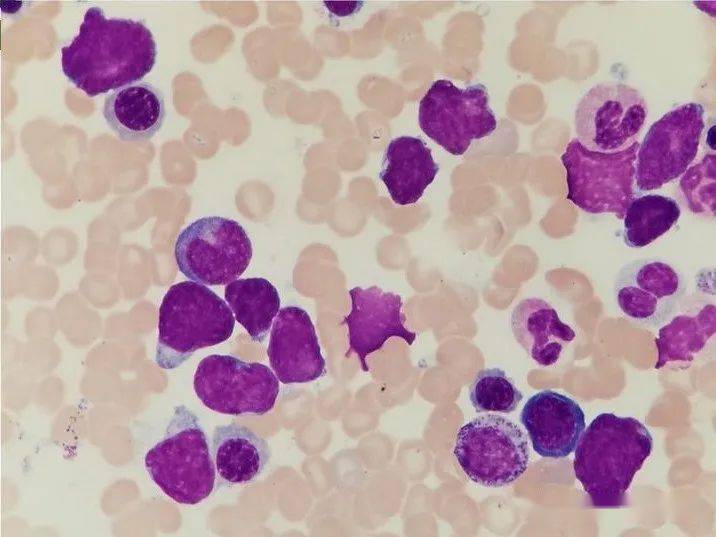
弥漫大b细胞淋巴瘤

大B

带"b"字的6大车标 老司机也不一定能说全
图片尺寸554x366
车型进行个性化生产,所改装后的奔驰车型就会换上巴博斯这个大b车标
图片尺寸640x360
换大b车标的wey想想都眼馋长城汽车与巴博斯汽车达成合作
图片尺寸1920x1080
保镖犬大b
图片尺寸268x381
x标锐志,虎啸标起亚,b标奔驰到底怎么回事?一篇文章全告诉你
图片尺寸640x427
林大b的微博头像
图片尺寸180x180
弥漫性大b细胞淋巴瘤(图源:imagebank.hematology.org)
图片尺寸550x412
坐这鸟人车全程拉个大b脸从来都没有说说笑笑的时候要是副驾驶换个别
图片尺寸720x1280
不是宾利却敢挂大b标,光是速度就让宾利"望闻问切"!
图片尺寸600x450
b大
图片尺寸1161x476
保镳犬大b
图片尺寸400x240
弥漫大b细胞淋巴瘤
图片尺寸699x525
b大
图片尺寸1170x570
富商花416万买辆宾利添越,朋友调侃其大b钥匙,车主不经捧腹
图片尺寸640x542
红牛杯采访船最爱大b zai妹盼8师傅教带妹
图片尺寸550x310
弥漫大b细胞淋巴瘤
图片尺寸716x537
大动作美军b52战略轰炸机成群紧急出动
图片尺寸930x510
ilovbee打造潮流外设新标杆大黄蜂b87震撼上市
图片尺寸1080x1381
2023款国六奔驰g63全车b7级防弹_凤凰网汽车_凤凰网
图片尺寸1440x1080
弥漫大b细胞淋巴瘤
图片尺寸716x539